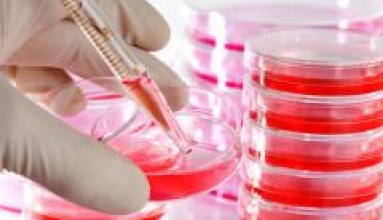

В России создадут медицинский лазер, не имеющий аналогов мире
В Государственном оптическом институте им. С.И. Вавилова завершили третий этап создания лазера, который позволит проводить прецизионные хирургические операции в офтальмологии, сможет применяться в сердечно-сосудистой и онкохирургии.